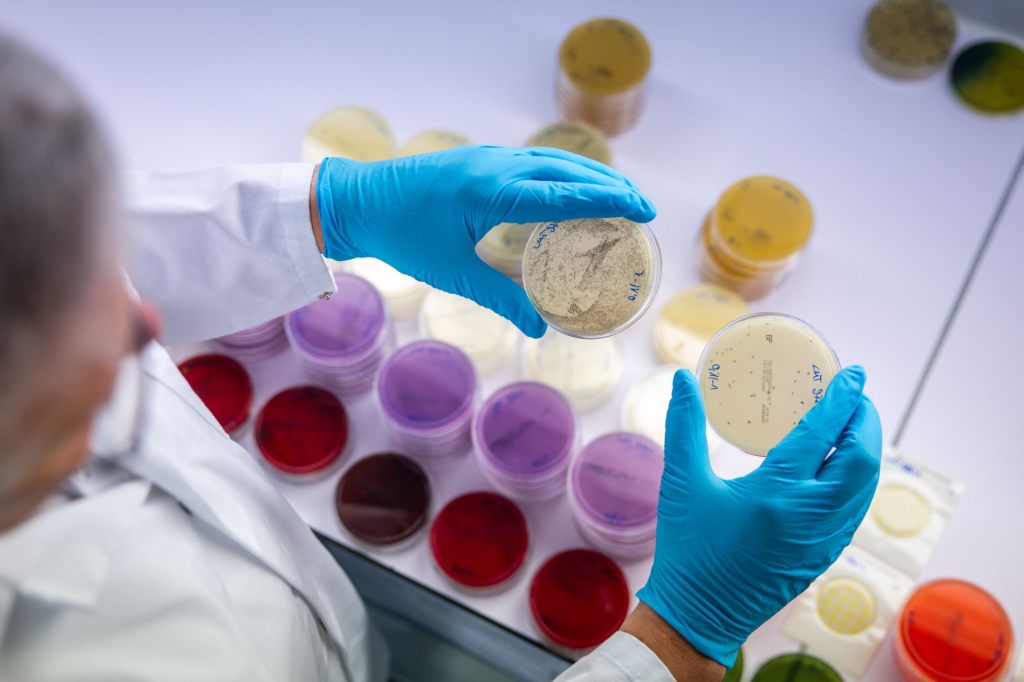
Bund vergibt künftig weniger aber höhere Exzellenz-Stipendien

Bund vergibt künftig weniger aber höhere Exzellenz-Stipendien
Baseljetzt
Der Bund reduziert künftig die Zahl der geförderten ausländischen Forschenden und Kunstschaffenden um rund ein Drittel, erhöht dafür aber die Förderbeträge pro Person.
Am Mittwoch wurde die entsprechende Verordnung angepasst. Die monatlichen Beiträge für talentierte ausländische Forschende und Kunstschaffende werden ab 1. Januar 2026 von 1920 auf 2450 Franken erhöht. Der einmalige Wohnkostenbeitrag wird von 300 auf 600 Franken angehoben, wie der Bundesrat mitteilte. Für Stipendiaten aus Ländern von ausserhalb der EU und der Efta übernimmt der Bund zusätzlich die Kranken- und Unfallversicherungsprämien.
Damit unter dem Strich nicht mehr Kosten anfallen, wird allerdings die Zahl der Stipendienplätze von heute 350 auf 200 bis 250 pro Jahr gesenkt. Der Bund will sich bei der Vergabe stärker auf Doktoratsstudien fokussieren. Ab dem akademischen Jahr 2027/2028 erhalten Post-Doktorierende keine Fördergelder mehr.
Die Exzellenz-Stipendien sind zur Deckung der Lebenshaltungskosten am Ausbildungsort gedacht. Vergeben werden sie seit 1961 in einem kompetitiven Verfahren. Ziel ist die Förderung wissenschaftlicher, kultureller und wissenschaftsdiplomatischer Beziehungen zwischen der Schweiz und dem Ausland. (sda/alr)
Mehr dazu
Feedback für die Redaktion
Hat dir dieser Artikel gefallen?
Kommentare lesen?
Um Kommentare lesen zu können, melde dich bitte an.


Kommentare
Dein Kommentar
Mit dem Absenden dieses Formulars erkläre ich mich mit der zweckgebundenen Speicherung der angegebenen Daten einverstanden. Datenschutzerklärung und Widerrufshinweise